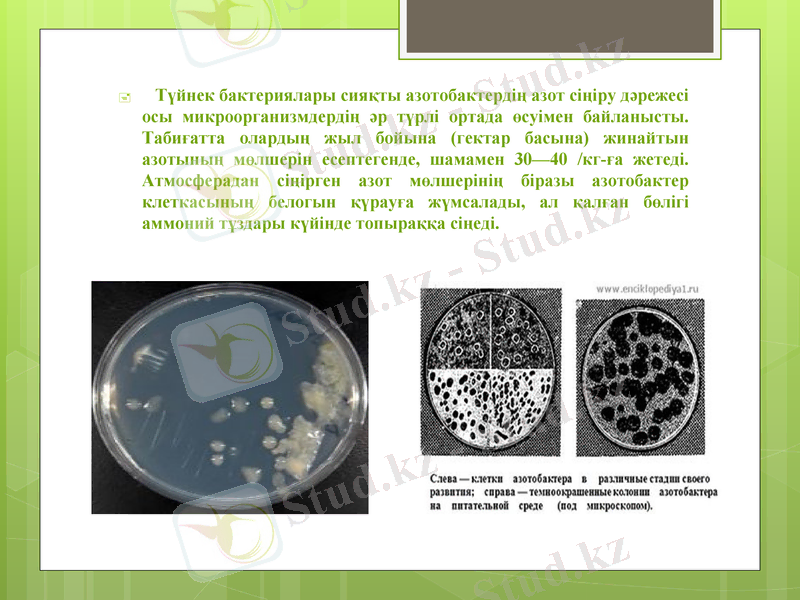
Slide 4

Азотобактерлердің азотты фиксациясы және биопрепараттарын өндіру мен ауыл шаруашылықтағы қолдану технологиялары



Азот және атмосферадағы азотты азотобактердің сіңіруі. Азот тыңайтқыштарын қолдан жасау технологиялары

Азот бактериясы
Азот бактерий
Azotobacter
Жеке күйінде азотобактер 1901 жылы бөлініп алынды. Содан бері олар жан-жақты зерттеліп . Соңғы жылдары, азотты тыңайтқыазотты фиксациялайтын минералды азотты тыңайтқыштарға балама ретінде биопрепараттар кеңінен штарды өндіру үшін қолданылатын шикізат бағасының қымбаттауы және оларды пайдалану қоршаған ортаның химиялық ластануы мүмкіндігін қалыптастырады. Осыған орай, азотфиксациялау механизмдерін және микроағзалар мен өсімдіктер арасындағы байланыстарын кең ауқымда зерттеу барысында, гендік инженерия әдістерін пайдалана отырып, ғалымдар азотфиксациялаудың жаңа жүйесін құру, атап айтқанда тиімділігі жоғары биопрепараттарды өндіру негізі туындады. Биопрепараттарды қолдану ауылшаруашылығы өсімдіктерінің өнімділігін арттырады, өсімдік құрамындағы ақуыз, крахмал, дәрумендер және басқа да қосылыстар құрамының артуы нәтижесінде өсімдік сапасын жақсартады, ерте өнім алуға және ұзақ уақыт сақтауға мүмкіндік туғызады.

Түйнек бактерия Клубеньковые бактерии Lotus pedunculatus
Ауылшаруашылық тәжірибесінде азотобактерин мен нитрагин кеңінен қолданылады. Азотобактерин Azotobacter тірі жасушаларының препараты болып табылады, ал нитрагин-түйнек бактерияларының препараты болып табылады. Бактериалды тыңайтқыштардың ішінен сонымен қатар фосфобактеринді де атап өтуге болады. Ол Bacillus megaterium var. рhosphaticumжасушалық препараты.
Азот бактериясы
Азот бактерий
Azotobacter
Түйнек бактериялары сияқты азотобактердің азот сіңіру дәрежесі осы микроорганизмдердің әр түрлі ортада өсуімен байланысты. Табиғатта олардың жыл бойына (гектар басына) жинайтын азотының мөлшерін есептегенде, шамамен 30-40 /кг-ға жетеді. Атмосферадан сіңірген азот мөлшерінің біразы азотобактер клеткасының белогын қүрауға жүмсалады, ал қалған бөлігі аммоний тұздары күйінде топыраққа сіңеді.

Азотобактерин топырақта еркін өмір сүретін бактериялардан дайындалатын препарат. Ол бактерияларды азотобактер деп атайды. Оның түйнек бактериясынан өзгешелігі өсімдік тамырында болмайды, түйнек түзбейді, тамыр айналасындағы топырақ қабатында жатып өседі. Азотобактер өзінің өсуі үшін, өсімдік тамырынан бөлінген заттарды және өсімдіктің өлген тамырларын пайдаланады.

Топырақты азотобактерин препаратын дайындау үшін азотобактерияларды әуелі температурасы 26 градус қоректік ортада көбейтеді де, 2-3 күннен соң көбейген азотобактерияларды жинап алып, үстіне су құяды да әбден араластырады. Сонан соң қайтадан топыраққа еңгізеді. Бұл топырақты жәшікке салып шаруашылыққа жібереді. Агарлы азотобактерин әзірлеу үшін қоректік ортаны қайнатады да жарты литрлік құмыраларға құяды. Салқындаған құмыра ішіндегі агар қоректік ортаға азотобактерияларды салып агарды жұқтырады. Осындай тәсілмен әзірленген әр құмырада 40-60 млн клетка болады.

Топырақты азотобактерин гектарына 3-6 кг есебімен, күздік және жаздық бидайдың, қант қызылшасының, көкөніс дақылдарының, картоптың тұқымымен бірге топыраққа еңгізіледі. Ол үшін 30 кг тұқымды бір литр суда шылайды. Шыланған тұқымға азотобактерин себіледі, араластырады. Егер азото-бактерин тұқымға жақсы жабысбаса, онда тұқымды тағы да шылап азотобактеринді екінші рет бүрку керек. Азотобактериннің тиімділігін арттыруда топырақ ылғалдылығы мен оның ауа режимі жақсы болу керек. Суармалы егіншілікте бұл жағдайды егісті дер кезінде суару және қатар аралығын өңдеу арқылы жасауға болады. Азотобактеринмен бірге топыраққа фосфор тыңайтқышын еңгізудің маңызы үлкен, өйткені фосфор бактериялардың азотты жинауын арттырады. Қызылша ауыспалы егісінде азотобактеринді бидайға, сондай-ақ күздік бидайдан соң егілетін қант қызылша егісіне пайдаланған дұрыс, өйткені ауыспалы егістің басқа дақылдарына қарағанда қант қызылшасы егісінде азоттың нитратты түрі аз болады.

Экономикасы дамыған елдер қазіргі уақытта яғни, ауылшаруашылығы өндірісінде химиялық қоспаларды қолданудан арылып, табиғи биологиялық таза әдістерді толық пайдалануды ұсынып отыр. Демек, бұл әдістің ерекшелігі сонда, топыраққа табиғи органикалық заттар өсімдік қалдықтарын ендіргенде және топырақты тыңайтатын өсімдіктерді егу арқылы топырақтың биологиялық белсенділігін арттыруға жауапты микроағзалардың тыныс-тіршілігін қадағалап реттеп отыруға мүмкіндік туады.

Еліміздің солтүстік бөлігіндегі топырақтарда азотобактерлер кездеспейді. Бірақ бүл жерлерді өңдесе олардың тіршілігіне қолайлы жағдай жасалады. Мәселен, Мурманск облысының өнделген және тың жерлерінің топырағынан алынған 370 үлгінің 102-сінен азотобактерлер табылған. Сонымен қатар олар Енисей аймағынан да табылды. Өңделген жерлердегі топырақтың бір грамындағы олардың саны жүзге дейін жетеді. Сибирьдің әр түрлі топырақтарын зерттеген Г. Н. Блинков азотобактерді көптеген топырақ типтерінен, соның ішінде шымды-күлгін топырақтардан да кездестірген.
- Іс жүргізу
- Автоматтандыру, Техника
- Алғашқы әскери дайындық
- Астрономия
- Ауыл шаруашылығы
- Банк ісі
- Бизнесті бағалау
- Биология
- Бухгалтерлік іс
- Валеология
- Ветеринария
- География
- Геология, Геофизика, Геодезия
- Дін
- Ет, сүт, шарап өнімдері
- Жалпы тарих
- Жер кадастрі, Жылжымайтын мүлік
- Журналистика
- Информатика
- Кеден ісі
- Маркетинг
- Математика, Геометрия
- Медицина
- Мемлекеттік басқару
- Менеджмент
- Мұнай, Газ
- Мұрағат ісі
- Мәдениеттану
- ОБЖ (Основы безопасности жизнедеятельности)
- Педагогика
- Полиграфия
- Психология
- Салық
- Саясаттану
- Сақтандыру
- Сертификаттау, стандарттау
- Социология, Демография
- Спорт
- Статистика
- Тілтану, Филология
- Тарихи тұлғалар
- Тау-кен ісі
- Транспорт
- Туризм
- Физика
- Философия
- Халықаралық қатынастар
- Химия
- Экология, Қоршаған ортаны қорғау
- Экономика
- Экономикалық география
- Электротехника
- Қазақстан тарихы
- Қаржы
- Құрылыс
- Құқық, Криминалистика
- Әдебиет
- Өнер, музыка
- Өнеркәсіп, Өндіріс
Қазақ тілінде жазылған рефераттар, курстық жұмыстар, дипломдық жұмыстар бойынша біздің қор #1 болып табылады.



Ақпарат
Қосымша
Email: info@stud.kz